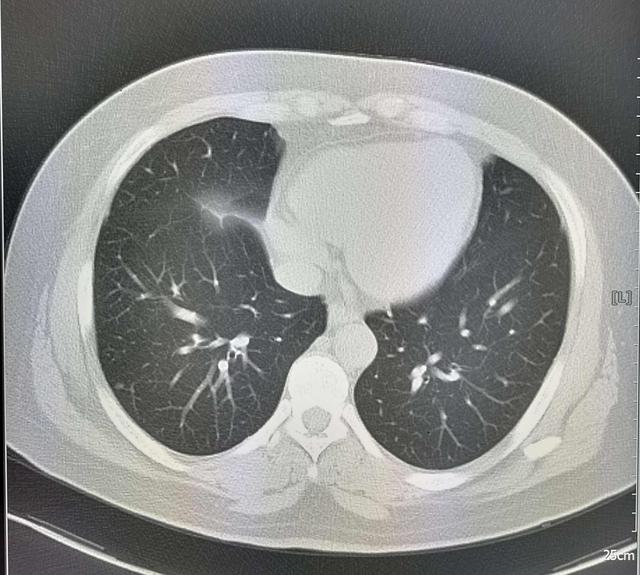
湿气越来越重的4个阶段，从湿疹到囊肿，你在哪个阶段了

文章图片

文章图片
大家好 , 我是中医刘家福!常看我视频的粉丝 , 应该都知道 , 我经常会说湿气生百病 , 很多囊肿患者之所以囊肿越长越大 , 越长越多 , 也都是因为体内湿气太重导致的 。 中医将体内湿气蕴结的严重程度 , 分为4个阶段 , 每个阶段的症状都是不同的 , 越往后啊 , 症状越严重 , 调理起来也越麻烦 。
第一阶段的湿气 , 症状不算太严重 , 就是头面部比较爱出油 , 可能还爱长湿疹 , 脾胃的消化功能也不太好 , 稍微吃多点就容易积食 。 这是脾虚导致的运化失常 , 水湿内停引起的 , 在治疗时 , 用一些健脾祛湿的中药就可以了 , 比如用陈皮、白术、荷叶、茯苓配伍着煮水喝 。
第二个阶段的湿气啊 , 是湿气内结没有及时的调理 , 导致湿入骨髓经络了 , 这时通常会有四肢乏力、常感疲累的症状 , 而且还会有湿气久聚成痰的问题 , 痰浊堆积在中焦 , 就会导致肥胖 , 如果你有大肚腩 , 很难减掉 , 那就说明你处在这个阶段了 , 在治疗时 , 不仅要用陈皮、白术等中药来健脾祛湿 , 还得用半夏、天南星等中药来化痰 。
第三阶段的湿气 , 已经进入脏腑了 , 如果脾胃充满湿气 , 就会有胃胀胃疼的症状 , 如果肺里充满湿气 , 就会导致肺的宣泄功能失常 , 你会一直咳嗽不止;如果湿气进入了子宫 , 就很容易导致宫颈炎、盆腔炎了 。 这个阶段的治疗 , 需要根据具体情况进行辨证 , 如果肺的湿气重 , 可以用复方鲜竹沥液来调理;如果是脾胃有湿气 , 就可以用参苓白术散来调理 。
第四阶段的湿气 , 是最严重的一个阶段 , 湿气久聚 , 源源不断的化生成痰浊 , 而痰和湿又一直阻碍气血运行 , 形成血瘀 , 痰湿和血瘀包裹在一起 , 会生成囊肿、结节、息肉等包块 , 而且因为体内湿气重 , 包块会长得很快 , 也会越长越多 , 患者同时还会有失眠、胃炎、胸闷腹胀等问题 。 这个阶段的治疗 , 得健脾祛湿 , 化痰破瘀 , 可以用八珍汤加味丹参、三棱、香附等中药 。
早期是湿气是比较好调理的 , 越往后病程越长 , 导致的问题也就越多 , 治疗起来相对复杂 , 所以建议大家啊 , 在发现症状后最好及时的调理 。
【湿气越来越重的4个阶段,从湿疹到囊肿,你在哪个阶段了】好了 , 今天就先分享到这 , 如果有相关问题 , 可以在评论区留言 。
- 湿气其实是吃出来的,建议收藏备用
- 9个腿越来越细的小习惯,要坚持下来哦
- 肚子越来越小的6个简单动作
- 越来越苗条的6个好习惯,看看你能做到几个?
- “注胶肉”越来越多?可能隐藏在这3种肉中,要学会辨别
- 痛风 搭配六味地黄丸 关节越来越好
- 司美格鲁肽,披露了减重的维持年限
- 赶走湿气的10个好习惯
- 脑出血越来越多,哈佛大学医学院:坚持做到这6件事,远离高血压
- 减肥到底有多费钱?医学专家告诉你如何优化减重的“账单”
